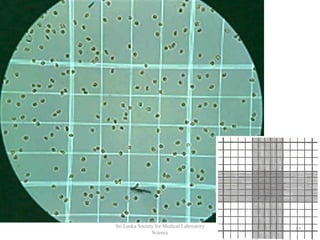
12
Sri Lanka Society for Medical Laboratory
Science

The document provides a comprehensive overview of hemocytometry, focusing on the measurement of red and white blood cells (RBCs and WBCs) using various techniques and equipment such as hemocytometers and pipets. It includes reference ranges for RBC and WBC counts, examples of dilutions, and counting rules for accurate results. Additionally, it emphasizes the proper care and handling of microscopes used in these measurements.